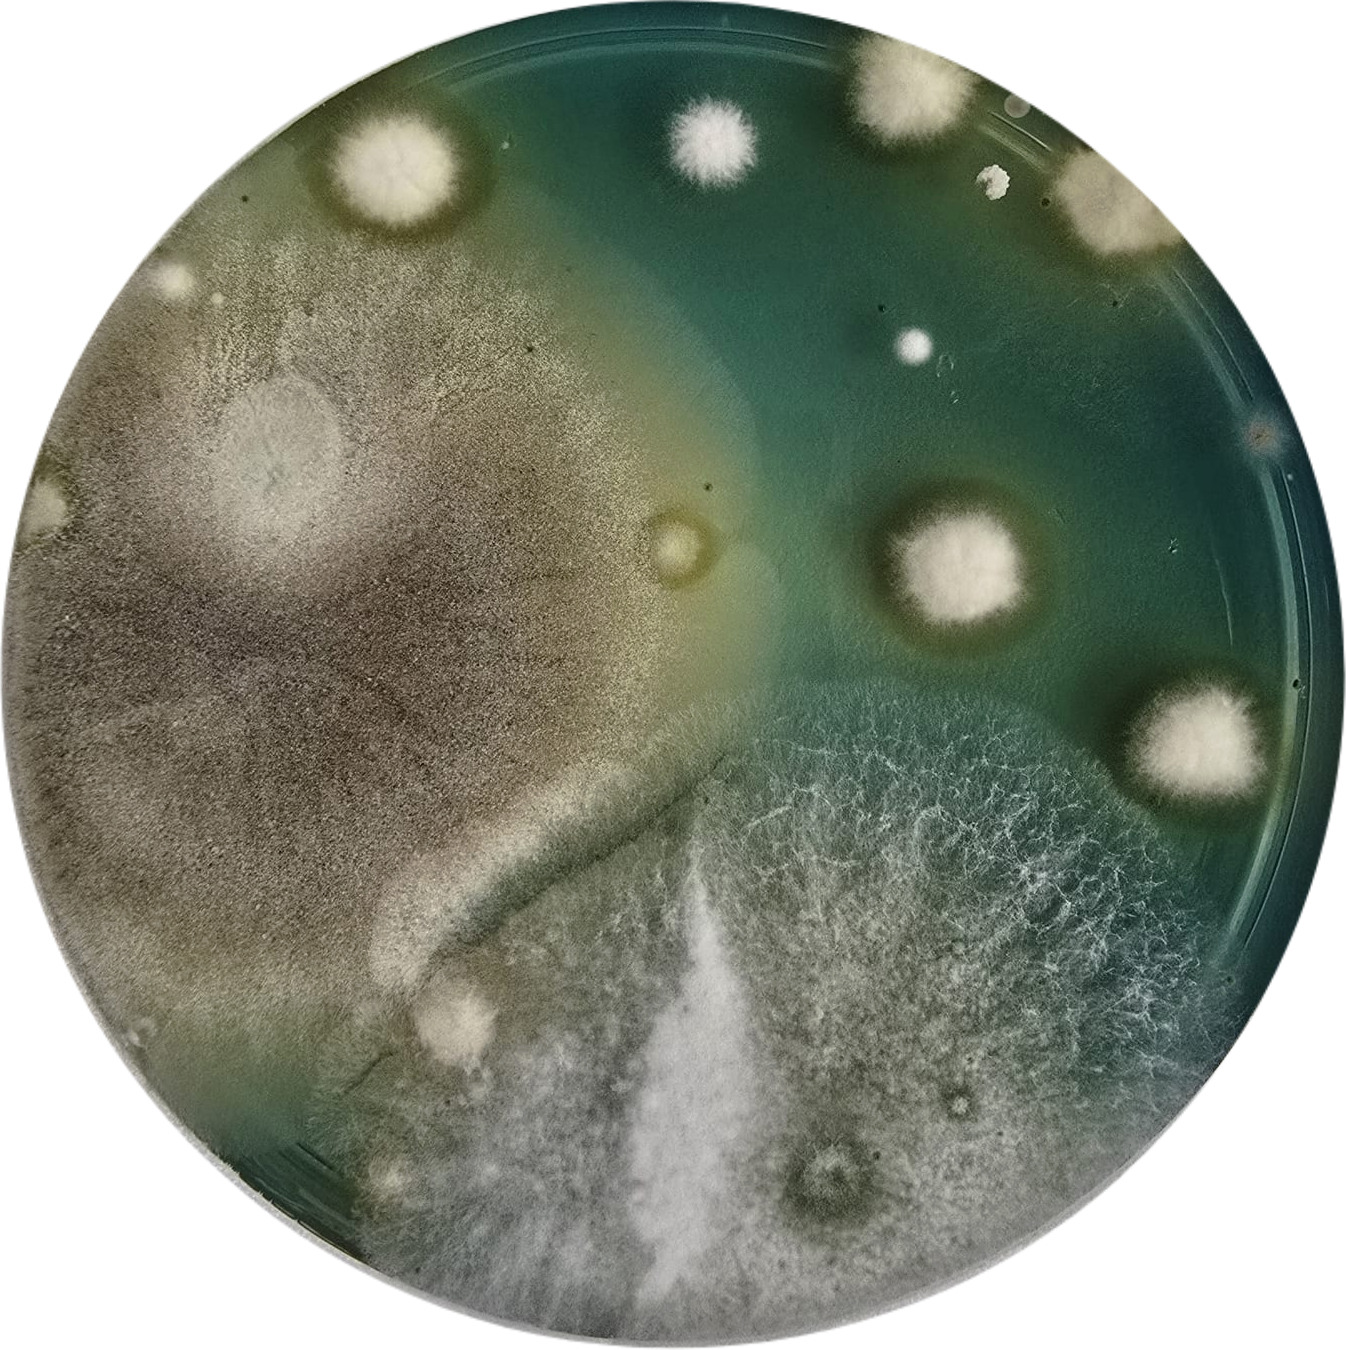
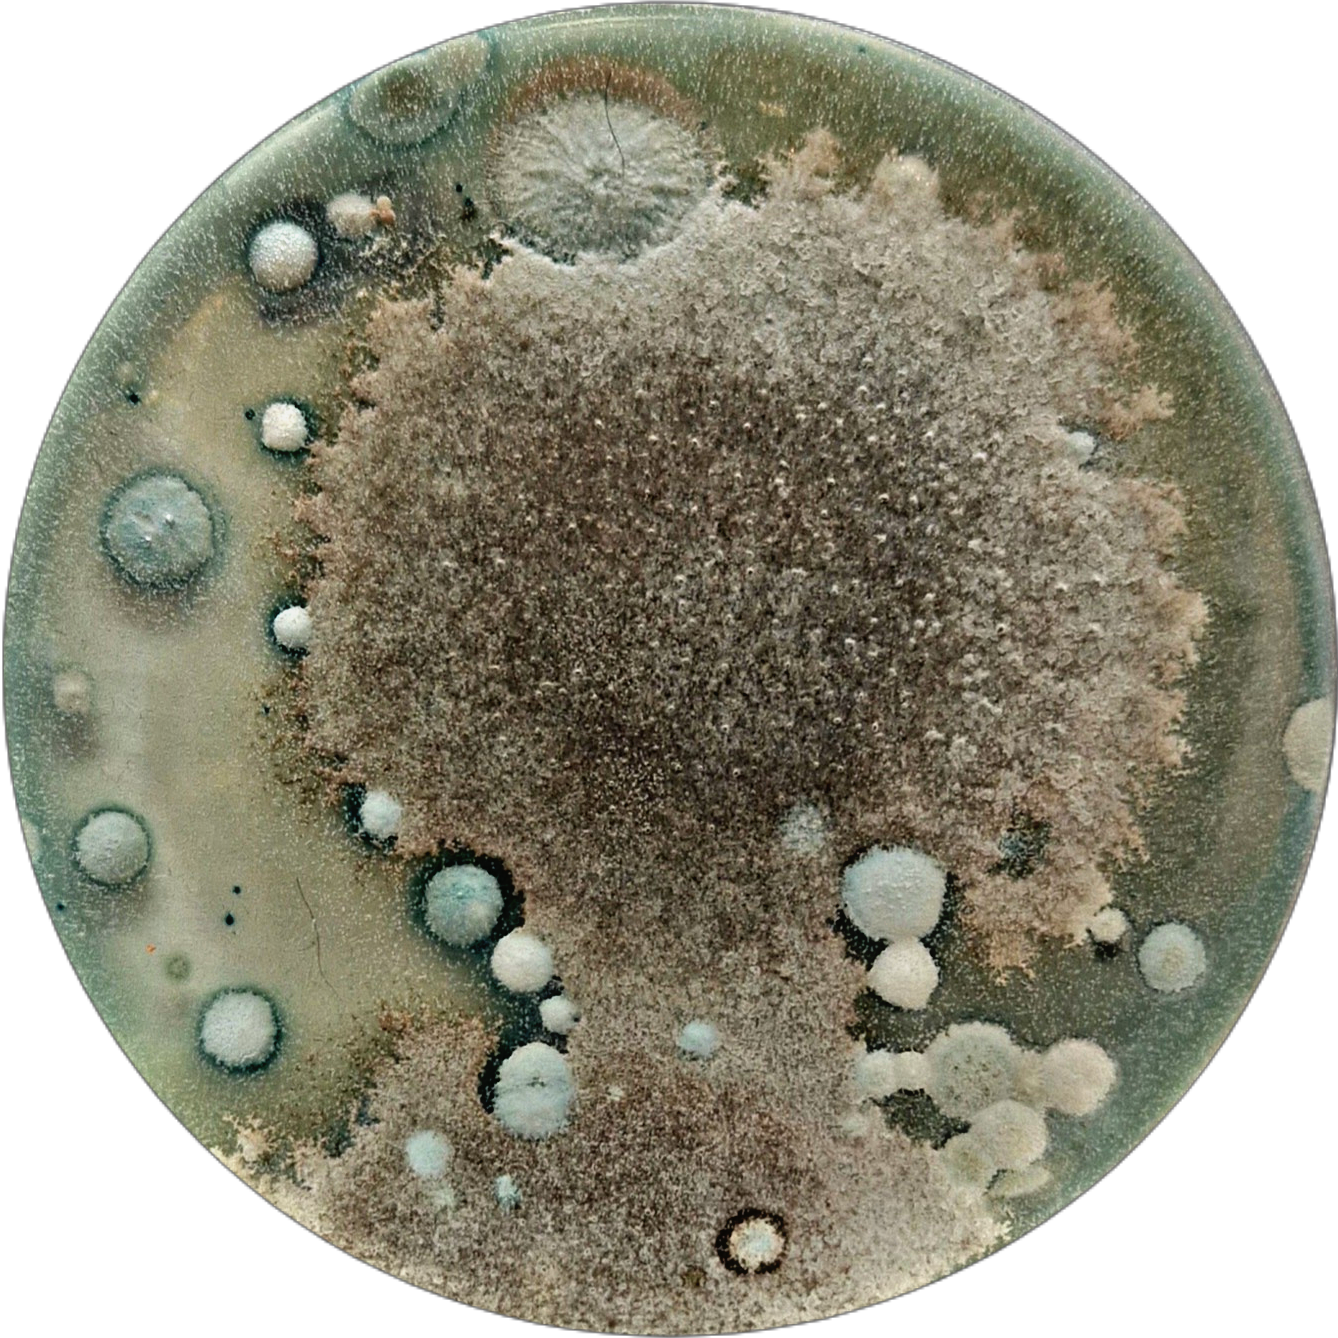

Agar Collection
Statement:
As a keen brewer, microbiologist and creative, I take joy in the finer details of the microbiological world. Here is a collection of photographs taken by myself and colleges showing the beauty of yeasts, molds and bacterial growths when given the optimum conditions to thrive. Don't worry, this does not reflect the hygiene standards of our brewery nor quality of our beer :)